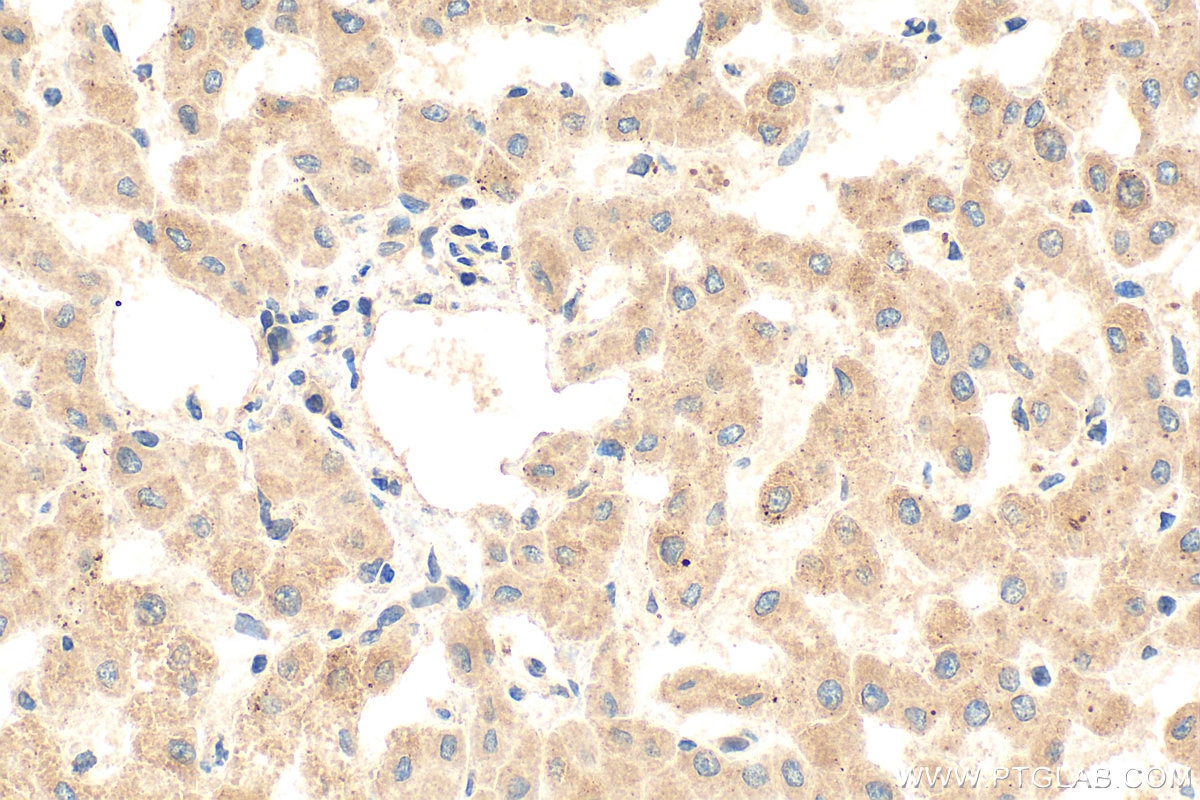
Immunohistochemistry (IHC) staining of human liver tissue using PIGO Polyclonal antibody (16369-1-AP)

Tested Applications
| Positive WB detected in | HeLa cells, A431 cells, COLO 320 cells, mouse spleen tissue, rat spleen tissue |
| Positive IHC detected in | human liver tissue, human kidney tissue, human skin tissue, human spleen tissue, human testis tissue Note: suggested antigen retrieval with TE buffer pH 9.0; (*) Alternatively, antigen retrieval may be performed with citrate buffer pH 6.0 |
| Positive IF/ICC detected in | MCF-7 cells |
Recommended dilution
| Application | Dilution |
|---|---|
| Western Blot (WB) | WB : 1:500-1:2000 |
| Immunohistochemistry (IHC) | IHC : 1:50-1:500 |
| Immunofluorescence (IF)/ICC | IF/ICC : 1:10-1:100 |
| It is recommended that this reagent should be titrated in each testing system to obtain optimal results. | |
| Sample-dependent, Check data in validation data gallery. | |
Published Applications
| WB | See 1 publications below |
Product Information
16369-1-AP targets PIGO in WB, IHC, IF/ICC, ELISA applications and shows reactivity with human, mouse, rat samples.
| Tested Reactivity | human, mouse, rat |
| Cited Reactivity | mouse |
| Host / Isotype | Rabbit / IgG |
| Class | Polyclonal |
| Type | Antibody |
| Immunogen |
CatNo: Ag9232 Product name: Recombinant human PIGO protein Source: e coli.-derived, PET28a Tag: 6*His Domain: 867-1089 aa of BC013987 Sequence: FLLLHLLAAGIPVTTPGPFTVPWQAVSAWALMATQTFYSTGHQPVFPAIHWHAAFVGFPEGHGSCTWLPALLVGANTFASHLLFAVGCPLLLLWPFLCESQGLRKRQQPPGNEADARVRPEEEEEPLMEMRLRDAPQHFYAALLQLGLKYLFILGIQILACALAASILRRHLMVWKVFAPKFIFEAVGFIVSSVGLLLGIALVMRVDGAVSSWFRQLFLAQQR Predict reactive species |
| Full Name | phosphatidylinositol glycan anchor biosynthesis, class O |
| Calculated Molecular Weight | 1089aa,119 kDa; 454aa,50 kDa |
| Observed Molecular Weight | 74 kDa |
| GenBank Accession Number | BC013987 |
| Gene Symbol | PIGO |
| Gene ID (NCBI) | 84720 |
| RRID | AB_2164806 |
| Conjugate | Unconjugated |
| Form | Liquid |
| Purification Method | Antigen affinity purification |
| UNIPROT ID | Q8TEQ8 |
| Storage Buffer | PBS with 0.02% sodium azide and 50% glycerol, pH 7.3. |
| Storage Conditions | Store at -20°C. Stable for one year after shipment. Aliquoting is unnecessary for -20oC storage. 20ul sizes contain 0.1% BSA. |
Background Information
PIGO (Phosphatidylinositol-glycan biosynthesis class O protein) is an enzyme crucial for attaching GPI anchors to proteins in the endoplasmic reticulum. PIGO encodes a 1,089 amino acid protein, that is involved in GPI biosynthesis (PMID: 22683086).
Protocols
| Product Specific Protocols | |
|---|---|
| IF protocol for PIGO antibody 16369-1-AP | Download protocol |
| IHC protocol for PIGO antibody 16369-1-AP | Download protocol |
| WB protocol for PIGO antibody 16369-1-AP | Download protocol |
| Standard Protocols | |
|---|---|
| Click here to view our Standard Protocols |
Publications
| Species | Application | Title |
|---|---|---|
Oxid Med Cell Longev Nrf2 Activation Attenuates Chronic Constriction Injury-Induced Neuropathic Pain via Induction of PGC-1α-Mediated Mitochondrial Biogenesis in the Spinal Cord. | ||
CNS Neurosci Ther Attenuation of neuronal ferroptosis in intracerebral hemorrhage by inhibiting HDAC1/2: Microglial heterogenization via the Nrf2/HO1 pathway | ||
Br J Pharmacol Inhibition of Brd4 alleviates osteoarthritis pain via suppression of neuroinflammation and activation of Nrf2-mediated antioxidant signalling |